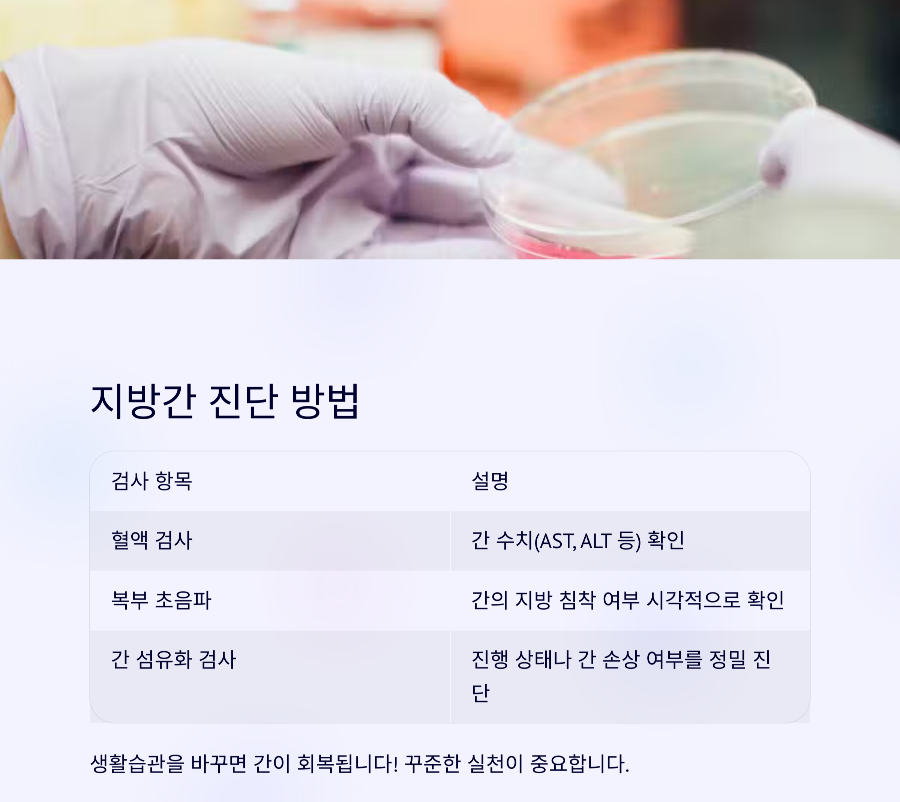

간 건강이 보내는 경고 신호, 어떻게 대처할까?
건강검진을 받고 "지방간 의심"이라는 말을 들었으면 당황스러울텐데요,
술도 많이 안 마시는데 왜? 하지만 요즘 같은 시대엔 술보다 생활습관이 더 큰 원인이라는 사실, 알고 계셨나요?
오늘은 지방간이 뭔지, 지방간 초기 증상이 어떻게 나타나는지, 그리고 쉽게 실천하는 개선 방법에 대해 정리해보겠습니다.
지방간이란?
지방간은 말 그대로 간에 지방이 과도하게 쌓인 상태를 말합니다.
간 무게의 5% 이상이 지방이면 지방간으로 진단되는데요,
술이 원인인 경우는 알코올성 지방간, 그렇지 않은 경우는 비알코올성 지방간이라고 부릅니다.
특히 비만, 당뇨, 고지혈증이 있는 분들은 비알코올성 지방간에 쉽게 노출될 수 있어요.
지방간 초기 증상
하지만 지방간은 초기엔 거의 증상이 없는 경우가 많아서 건강검진 없이는 발견이 어렵습니다.
피로하다 싶을 땐 검진부터 받아보는 게 좋아요.
- 만성 피로, 쉽게 지치는 느낌
- 오른쪽 윗배에 둔한 통증이나 불편감
- 식욕 저하 또는 소화불량
- 체중 증가 또는 갑작스런 체중 변화
이런 증상이 지속된다면 단순한 피로나 스트레스가 아닌 간 기능 저하의 신호일 수 있어 주의가 필요합니다.
지방간 진단 방법
| 검사 항목 | 설명 |
|---|---|
| 혈액 검사 | 간 수치(AST, ALT 등) 확인 |
| 복부 초음파 | 간의 지방 침착 여부 시각적으로 확인 |
| 간 섬유화 검사 | 진행 상태나 간 손상 여부를 정밀 진단 |
지방간 개선 방법
생활습관을 바꾸면 간이 회복됩니다!
아래 실천 방법들을 꾸준히 유지하면 간 건강이 눈에 띄게 개선될 수 있습니다.
아래 실천 방법들을 꾸준히 유지하면 간 건강이 눈에 띄게 개선될 수 있습니다.
1. 식단 개선
- 기름진 음식, 인스턴트, 당분 많은 음식 줄이기
- 채소, 두부, 생선 등 담백한 단백질 섭취
- 과식 피하고, 야식 습관 고치기
2. 운동 습관 들이기
- 주 3회 이상, 하루 30분 유산소 운동 (걷기, 자전거 등)
- 근육량 늘리는 가벼운 근력 운동도 병행
3. 체중 감량
전체 체중의 5~10%만 줄여도 간 수치가 눈에 띄게 좋아집니다.
무리한 다이어트보다, 천천히 감량하는 것이 중요합니다.
4. 음주 조절
술을 자주 마시는 편이라면 일단 한 달 금주부터 실천해보세요.
알코올성 지방간이라면 이 방법만으로도 회복이 빠릅니다.

체크리스트로 정리!
- 피로하고 무기력한 느낌이 지속된다면 검진 받기
- 식습관부터 점검 – 기름진 음식 줄이고 균형 잡기
- 운동 루틴 만들기 – 걷기부터 시작!
- 간에 무리를 주는 음주 습관 줄이기
- 연1회 정기 검사
하루 한 잔, 커피도 도움이 될 수 있다?
"커피가 간에 좋다?"는 말, 일리가 있습니다.
무가당 블랙커피는 간 효소 수치를 낮추고 염증 완화에 도움을 줄 수 있어 하루 1~2잔까지는 간 건강에 긍정적인 영향을 줍니다.
단, 설탕이나 프림이 들어간 커피는 피해야 합니다.
오늘도 내 몸을 아끼는 하루 되시길 바랍니다 :)
'건강정보' 카테고리의 다른 글
| BMI 지수 계산법부터 정상 범위까지 한눈에 정리 (2) | 2025.05.04 |
|---|---|
| 콜레스테롤 정상 수치와 좋은 vs 나쁜 콜레스테롤 비교 (1) | 2025.05.03 |
| 간수치 상승 원인과 증상, 정상범위 총정리 (0) | 2025.05.02 |
| 비타민D 부족 증상, 혹시 당신도? (1) | 2025.05.02 |
| 보건증 인터넷 발급, 비용과 검사항목 정리 (2) | 2025.04.25 |